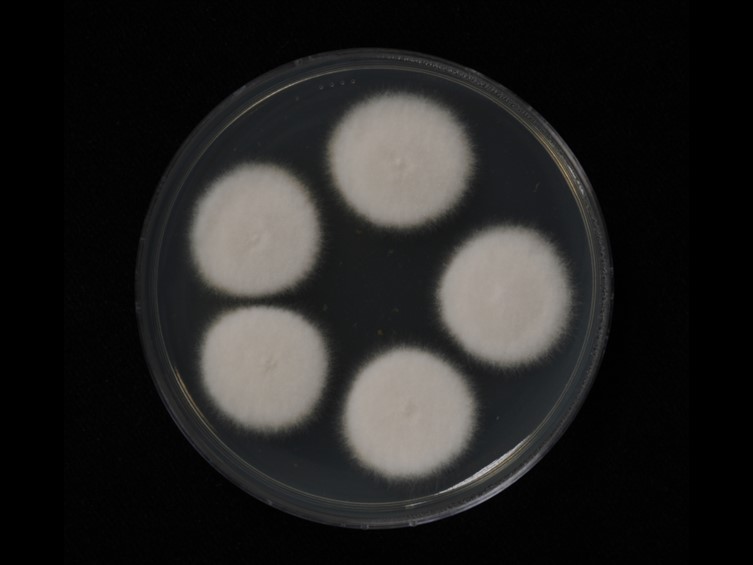

Habitat:
Underside of dicotyledonous leaves.
Host:
Whitefly nymphs (Aleyrodidae).
Description:
 Stromata white, completely covering the host, ca 900-1200 μm in diam.
Stromata white, completely covering the host, ca 900-1200 μm in diam.  Perithecia developing either on the edges of the stroma, elongated flask-shaped to conical, white turing cream with age, up to 750 μm long.
Perithecia developing either on the edges of the stroma, elongated flask-shaped to conical, white turing cream with age, up to 750 μm long.  Asci cylindrical, 700 μm long × 3.5 μm wide.
Asci cylindrical, 700 μm long × 3.5 μm wide.  Ascospores filliform, whole, 350-600 × 1 μm.
Ascospores filliform, whole, 350-600 × 1 μm.
Culture characteristics:
Colonies on PDA attaining 30–40 mm in diam after 14 d, white, floccose with cream reverse.
Colonies on PDA attaining 30–40 mm in diam after 14 d, white, floccose with cream reverse.
Other Available strains
TBRC 8344 , TBRC 8360Reference:
Hywel-Jones NL (1993). Torrubiella luteorostrata, a pathogen of scale insects and its association with Paecilomyces cinnamomeus with a note on Torrubiella tenuis. Mycological Research 97: 1126–1130.
DOI: https://doi.org/10.1016/S0953-7562(09)80514-5Johnson D, Sung G-H, Hywel-Jones NL, et al. (2009). Systematics and evolution of the genus Torrubiella (Hypocreales, Ascomycota). Mycological Research 113: 279–289.
DOI: https://doi.org/10.1016/j.mycres.2008.09.008Petch T (1922). Interim notes on entomogenous fungi. Annals of the Royal Botanic Gardens Peradeniya 7: 323–327
DOI: https://doi.org/10.3114/sim.2007.57.01referencesสีน้ำตาลและเขียวไม่มีDOIPetch, T. (1923). Studies in entomogenous fungi. Transactions of the British Mycological Society 9: 108–128.
Sung, G-H, Hywel-Jones NL, Sung J-M, et al. (2007). Phylogenetic classification of Cordyceps and the clavicipitaceous fungi. Studies in Mycology 57: 5–59.
Species |
Strain |
Compound |
Pubchem CID |
Biological activity |
Reference |
|---|---|---|---|---|---|
| Conoideocrella tenuis | TBRC 8360 | Conoideocrellide A (1) | 159931 | Antimicrobial acitvity against S. aureus; Antimicrobial acitvity against E. coli | Isaka et al. 2011 |
| Conoideocrella tenuis | TBRC 8360 | Conoideocrellide B (2) | 159931 | Antimicrobial acitvity against S. aureus; Antimicrobial acitvity against E. coli | Isaka et al. 2011 |
| Conoideocrella tenuis | TBRC 8360 | Conoideocrellide C (3) | 159931 | Antimicrobial acitvity against S. aureus; Antimicrobial acitvity against E. coli | Isaka et al. 2011 |
| Conoideocrella tenuis | TBRC 8360 | Conoideocrellide D (4) | 159931 | Antimicrobial acitvity against S. aureus; Antimicrobial acitvity against E. coli | Isaka et al. 2011 |
| Conoideocrella tenuis | TBRC 8360 | Hopane-27-al-6β,11α,22-triol (5) | 159931 | Antimicrobial acitvity against S. aureus; Antimicrobial acitvity against E. coli | Isaka et al. 2011 |
| Conoideocrella tenuis | TBRC 8360 | Hopane-6β,11α,22, 27-tetraol (6) | 159931 | Antimicrobial acitvity against S. aureus; Antimicrobial acitvity against E. coli | Isaka et al. 2011 |
| Conoideocrella tenuis | TBRC 8360 | Hopane-6β,7β,22-triol (7) | 159931 | Antimicrobial acitvity against S. aureus; Antimicrobial acitvity against E. coli | Isaka et al. 2011 |
| Conoideocrella tenuis | TBRC 8360 | Zeorin (8) | 159931 | Antimicrobial acitvity against S. aureus; Antimicrobial acitvity against E. coli | Isaka et al. 2011 |
| Conoideocrella tenuis | TBRC 8360 | Atropisomer of ES-242-2 (9) | 159931 | Antimicrobial acitvity against S. aureus; Antimicrobial acitvity against E. coli | Isaka et al. 2011 |
| Conoideocrella tenuis | TBRC 8360 | New bioxanthracene derivative (10) | 159931 | Antimicrobial acitvity against S. aureus; Antimicrobial acitvity against E. coli | Isaka et al. 2011 |
| Conoideocrella tenuis | TBRC 8360 | ES-242-1 (11) | 159931 | Antimicrobial acitvity against S. aureus; Antimicrobial acitvity against E. coli | KNOWN: Jaturapat et al. 2001 |
| Conoideocrella tenuis | TBRC 8360 | ES-242-2 (12) | 159931 | Antimicrobial acitvity against S. aureus; Antimicrobial acitvity against E. coli | KNOWN: Jaturapat et al. 2001 |
| Conoideocrella tenuis | TBRC 8360 | 6,8-Dihydroxy-5-methoxy-3-methylisocoumarin 6-O-(4- O-methyl-β-D-glucopyranoside) (13) | 159931 | Antimicrobial acitvity against S. aureus; Antimicrobial acitvity against E. coli | KNOWN: Jaturapat et al. 2001 |
| Conoideocrella tenuis | TBRC 8344 | Isocoumarin glucoside 1 (14) | 159931 | Antimicrobial acitvity against S. aureus; Antimicrobial acitvity against E. coli | Kornsakulkarn et al. 2009 |
| Conoideocrella tenuis | TBRC 8344 | Isocoumarin glucoside 2 (15) | 159931 | Antimicrobial acitvity against S. aureus; Antimicrobial acitvity against E. coli | Kornsakulkarn et al. 2009 |
| Conoideocrella tenuis | TBRC 8344 | Isocoumarin glucoside 3 (16) | 159931 | Antimicrobial acitvity against S. aureus; Antimicrobial acitvity against E. coli | Kornsakulkarn et al. 2009 |
| Conoideocrella tenuis | TBRC 8344 | 6,8-dihydroxy-3-methylisocoumarin (17) | 159931 | Antimicrobial acitvity against S. aureus; Antimicrobial acitvity against E. coli | Kornsakulkarn et al. 2009 |
| Conoideocrella tenuis | TBRC 8344 | 6,8-dihydroxy-3-hydroxymethylisocoumarin (18) | 159931 | Antimicrobial acitvity against S. aureus; Antimicrobial acitvity against E. coli | Kornsakulkarn et al. 2009 |
|
Strain |
LSU | TEF1 |
|---|---|---|
| BCC 53676 | KJ435076 | KJ435096 |